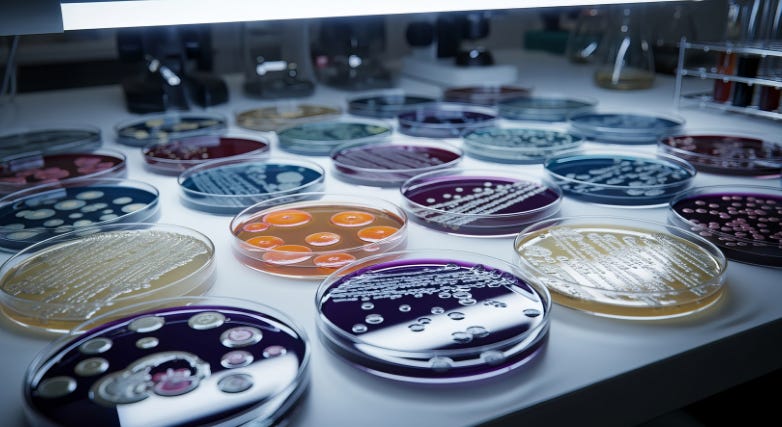

Our Friends in the Lab: A Lab Week Tribute
Celebrating Lab Week and the people who make sense of what we collect
by Shanise Keith • April 21, 2026
Management, Phlebotomy History
I talk about phlebotomy for a living. I’ve been teaching it, writing about it, and testifying about it in legal cases for many years now. I know the pre-analytical phase of laboratory testing as well as the back of my own hand. And yet, I sat in a conference room at an ASCLS-CO event last October and had my mind completely blown — not once, but twice — by two young women who work in the lab.
I was there as a speaker. I ended up as a student.
The first speaker was Ayla, MLS(ASCP)CM, a microbiologist with four years of experience working exclusively in microbiology at a Colorado hospital. Ayla talked about innovations in automated microbiology systems and digital plate reading — technology that is changing how labs identify pathogens and report results. She described how these new machines were being implemented at the facilities where she had worked, the advantages and disadvantages, how they affected the daily workflow, and how they simplified and sped up certain aspects of culture testing. Nearly every hand in the room went up with questions about how things had been done in the past versus how the new process handled them now.
Ayla had an answer for every single one. She was not a representative of the company selling these machines. She was simply well-trained, deeply knowledgeable, and clearly passionate about her field. She was teaching things to women with decades of lab experience who were leaning forward in their seats. The energy in the room was lively, and her excitement to share about her daily work was electric. It was heartwarming to watch a room full of people hang on every word of a lecture that most people would assume was dry — I have sat through similar topics barely keeping my eyes open. She had the room enthralled.
The second was Hayley, MLS(ASCP)CM, who has spent the last six-plus years working the night shift in the Blood Bank at a children’s hospital. Hayley walked us through the process of performing newborn blood type workups — specifically what happens when that newborn has AB negative blood and clinically significant maternal antibodies present. She gets one drop of plasma from a whole blood sample. One drop. That drop gives her roughly two dozen tiny samples to use for the entire workup in reverse antibody testing.
In the scenario she walked us through — and my apologies, Hayley, if I get some of these details wrong — I believe the newborn had been life-flighted to the hospital, was dealing with serious life-threatening complications, and had already reached the maximum safe blood collection volume for various tests. No mother present for testing either. That means no do-overs, no sending someone back for another sample. One drop of plasma to determine the blood type through a process I had no idea was so complicated.
I had always imagined that we send a sample to the lab, they put it in a machine, and bam — blood type confirmed. I was wrong.
The process she walked us through was methodical, precise, and unforgiving. It takes focused, careful time to rule out each antibody one by one. No popping it in a machine and waiting for a beep — she works through every step herself. Every variable has to be considered. Every possibility has to be ruled out. And the stakes couldn’t be higher: this is a newborn, possibly hours old, whose blood type and antibody status will directly affect clinical decisions about their care. Hayley described it matter-of-factly, the way people do when they’ve internalized something so completely it no longer registers as remarkable. What she was describing sounded more like disarming a bomb than what I had imagined my whole career.
I sat there thinking about heel sticks. About tiny 24 gauge IVs placed in a scalp vein, blood dripping into a microcollection container — a method that, while sometimes necessary, carries a real risk of hemolysis in those already precious few drops. About the phlebotomists and nurses collecting those specimens — the tiny volumes, the careful technique required, the absolute criticality of not hemolyzing that sample. A hemolyzed specimen from a bad collection isn’t just an inconvenience. In this context, it could mean compromising the only plasma available for a workup that cannot be repeated.
For my part, I have been the one at the bedside drawing blood from a freshly delivered baby — sometimes so fresh they are still covered in wet baby goo (vernix). You always know that blood is precious cargo. I never knew what the lab scientist was going through in their windowless room on the other side of that specimen.
Both of them were young. Both of them were passionate in a way that was genuinely contagious. Both of them clearly care very deeply about their careers and their patients. It filled me with hope, excitement for the future of healthcare, and a renewed appreciation for all of our friends in the lab.
A Week Worth Knowing About
Medical Laboratory Professionals Week — Lab Week, as most people in healthcare call it — runs April 19–25 this year. Lab Week has a history worth knowing, because in many ways it’s the origin story of the world phlebotomy grew out of.
Clinical laboratory science as a formal profession began taking shape in the early twentieth century. Hospitals scrambling to meet accreditation requirements after World War I needed trained laboratory staff, and by the 1930s, the American Society for Medical Technology — what would eventually become the American Society for Clinical Laboratory Science, or ASCLS — was established to represent them. The profession was growing, but it was largely invisible. Physicians ordered the tests and received the results. The people doing the work in between went unrecognized.
That changed in 1975, when ASCLS inaugurated the very first National Medical Laboratory Week — a deliberate, organized effort to say: we exist, this work matters, and the public deserves to know who is doing it. Today the week is coordinated by a coalition of 18 national laboratory organizations — ASCLS and ASCP among the most prominent — and celebrated in hospitals, clinics, and labs across the country every April. The 2026 theme is “Lab Story: To Infinity and Beyond for Our Patients.” Having sat in a room listening to Hayley and Ayla, I can tell you that theme lands.
One Chain, No Weak Links
Here is what I want phlebotomists to understand, and what I want our friends in the lab to know we understand: what we do and what they do are not separate things. They are one continuous process, and every link matters.
Consider what happens when a blood culture is drawn with poor technique — skin flora introduced into the bottle, aseptic protocol skipped or rushed. That contaminated culture doesn’t just create extra work. It can trigger a cascade: a clinician chasing a false positive infection, a patient started on antibiotics they may not need, days of anxiety and unnecessary treatment while the repeat culture processes. Behind every contaminated blood culture result is a collection that didn’t meet the mark. Ayla lives on the receiving end of that. She analyzes the cultures, identifies types of growth and provides critical information for diagnosis and treatment. She catches the false positives and prevents unnecessary antibiotics, longer hospital stays, and physician frustrations.
The same is true for Hayley’s world. The roughly two dozen samples she works with from a single drop of neonatal plasma don’t appear out of thin air — they come from an infant who cannot tell the phlebotomist if it hurts, who must use technique careful enough not to hemolyze that sample. A hemolyzed neonatal specimen doesn’t just complicate the result — it may render that plasma unusable entirely, leaving the lab to make critical decisions with even less to work with. The lab result is only as good as the collection that preceded it. We know this. We teach it. But hearing it from the other side — from someone who lives with the consequences of our work every single shift — makes it real in a different way.
Phlebotomists who understand what happens to their specimens after they leave the collection site are better collectors. The more we know about each other’s world, the better we each do our jobs.
Lab Week is a celebration of the people who work largely out of sight, running the tests that drive an estimated 70 percent of all clinical decisions. Phlebotomists are the first chapter of every one of those stories. The lab worker is the chapter that makes sense of it.
Happy Lab Week to all of our friends in the lab — and a particular thank-you to Hayley and Ayla, who reminded a room full of experienced healthcare professionals that there is always more to learn, and that with people like those two, the future is bright.
Please take a few minutes to stop by your lab and thank our friends who do such critical work and rarely get any appreciation.
Related Posts and Information
overall rating: my rating: log in to rate